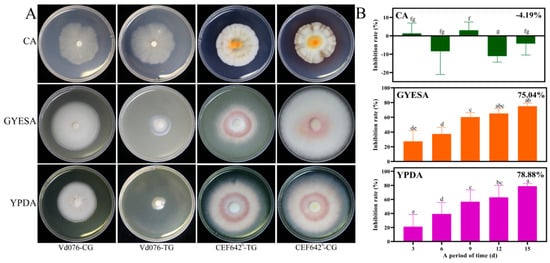

Abstract
Verticillium wilt is a devastating soil-borne disease that significantly impacts cotton production, necessitating the development the effective biofumigants for its control. In this study, the inhibitory effect of total volatile organic compounds (VOCs) produced by Talaromyces purpureogenus CEF642N against Verticillium dahliae were evaluated using the one strain many compounds (OSMAC) strategy and analyzed through volatile metabolome. CEF642N was found to produce two primary VOCs, 3-octanol and 2-octenal, (E)-, both of which demonstrated significant antifungal activity. Transcriptome analysis of mycelium grown on various solid media revealed notable differences in the expression of genes associated with arachidonic acid metabolism, lipoxygenase (LOX), and lytic enzymes. These findings provide a foundation for future research aimed at identifying key genes involved in the eight-carbon volatile biosynthetic pathway.
1. Introduction
Verticillium dahliae is a soil-borne hemibiotrophic fungus responsible for causing vascular disease in plants, leading to significant economic losses worldwide. This pathogen infects over 400 dicotyledon plant species, including annual herbs, perennials, and woody plants. In cotton crops, Verticillium wilt alone results in an average yield reduction of 10–35% [1]. Plant diseases, in general, contribute to substantial global crop losses, adversely affecting both the quality and quantity of agricultural produce. In response to the global shift toward reducing chemically synthesized pesticides, plant disease management has increasingly relied on biocontrol technologies, strategies, and approaches. Fungal antagonists, in particular, play a critical role in controlling plant pathogens and are widely utilized as biocontrol agents [2]. Fungal volatile organic compounds (VOCs) have emerged as a promising alternative to chemical pesticides, offering potential benefits for crop protection and overall plant health.
The application of fungal VOCs as pesticide alternatives has garnered considerable attention [3,4]. For instance, VOCs produced by Trichoderma atroviride inhibit the growth of Phytophthora infestans and induce significant morphological and ultrastructural damage to its mycelium, including cell deformation, collapse, and organelle destruction [5]. Similarly, 6-pentyl-2H-pyran-2-one, a VOC from Trichoderma erinaceum, strongly suppresses the growth and sporangial germination of Peronophythora litchii, causing severe intracellular damage [6]. Citronellol, produced by Kluyveromyces marxianus YG-4, inhibits Penicillium expansum by damaging cell structures, disrupting redox system, reducing antioxidant enzymes activity, and inducing oxidative damage [7].
These VOCs, which function as antimicrobial “weapon systems” for fungi, are produced under specific environmental conditions or during particular stages of the fungal life cycle. However, replicating these complex conditions in laboratory settings remains challenging, thereby limiting our ability to exploit the chemical diversity of fungi. Consequently, only a fraction of fungal secondary metabolites (SMs) has been characterized, leaving significant potential for the discovery of novel bioactive compounds [8,9]. The one strain many compounds (OSMAC) approach, which involves systematically altering culture conditions, has proven effective in exploring microbial SMs diversity [10]. This strategy can activate silent gene clusters in microorganisms, leading to the production of additional SMs. Due to its simplicity and efficacy, the OSMAC approach has been widely adopted [11,12].
Advances in genetics and bioinformatics have further enhanced natural product discovery. Integrating genomic and transcriptomic technologies provides a practical and efficient strategy to overcome the limitations of traditional methods. For instance, comparative transcriptome analysis can inform the optimization of fungal culture conditions to improve the yield of target compounds [13].
In this study, the OSMAC strategy was employed to investigate the VOCs produced by Talaromyces purpureogenus CEF642N across three different media. The VOCs exhibited varying inhibition rates against V. dahliae, and the underlying reasons for these differences were explored through comparative analyses of their volatile metabolomes. Two major VOCs demonstrated significant inhibitory effects on hyphae growth and spore germination. Additionally, comparative transcriptome analyses were conducted to identify potential genes involved in their biosynthesis, providing a foundation for future research into the production and application of these compounds.
2. Materials and Methods
2.1. Strains and Culture Conditions
The antagonist strain CEF642N, used in this study, is an endophytic fungus isolated from healthy cotton roots and identified as Talaromyces purpureogenus through morphology analysis and ITS sequencing [14]. The pathogenic strain Verticillium dahliae (accession number Vd076) was isolated from cotton plants exhibiting Verticillium wilt and was identified as a pathogenic strain [15]. The compositions of the various media used in this study are provided in Supplementary Materials Table S1.
2.2. Inhibitory Activity of Total VOCs from Different Media
The antagonistic effect of VOCs produced by CEF642N on V. dahliae was evaluated using a double Petri dish assay [16]. In the treatment group, one Petri dish was inoculated with a 5 mm plug of the antagonistic fungus (CEF642N), while the other contained a 5 mm plug of the pathogenic fungus (V. dahliae). Both dishes were filled with the same medium, then docked face-to-face with CEF642N oriented upward and V. dahliae oriented downward, followed by parafilm sealing for co-cultivation. In the control group, only the pathogenic fungus was inoculated and cultivated independently. All cultures were incubated at a constant temperature of 25 °C for 15 days. Colony diameters were measured and photographed every 3 days, with each experiment repeated five times. The inhibition rate was calculated using the following formula:
where Cd represents the colony diameter of the control group minus 5 mm, and Td represents the colony diameter of the treatment group minus 5 mm.
2.3. Identification of VOCs Produced by CEF642N from Different Media
Strain CEF642N was cultivated on Czapek agar (CA), glucose yeast extract soluble starch agar (GYESA), and yeast extract peptone dextrose agar (YPDA) media at 25 °C for 15 days. Mycelium was scraped from the medium surface using a sterile scalpel and 150 mg aliquots were transferred into 20 mL headspace (HS) vials containing 10 μL of 2-octanol as the internal standard for relative VOC quantification.
SPME conditions: The PAL (Prep And Load) rail system was programmed with the following solid-phase microextraction (SPME) parameters: incubation temperature of 60 °C, consisting of 15 min preheating, 30 min incubation, and 4 min desorption.
GC-MS configuration: An Agilent 7890 gas chromatograph (GC) coupled to a 5977B mass spectrometer (MS) was employed. Chromatographic separation used a DB-Wax column (30 m × 250 μm × 0.25 μm) with helium carrier gas at 1 mL/min. The oven temperature program initiated at 40 °C (hold 4 min), ramped at 5 °C/min to 245 °C (hold 5 min). Electron Impact (EI) ionization was performed at −70 eV. Compound identification utilized the NIST library [14].
2.4. In Vitro Antifungal Activity Assay
To evaluate the antifungal activity of VOCs differentially produced in GYESA and YPDA media, we conducted mycelial growth inhibition assays using commercial standard compounds: 3-octanol and 2-octenal, (E)-. The experimental setup was adapted from the confrontation culture method with modifications [17]. In place of the direct application of biocontrol fungus, we positioned Oxford cups containing graded volumes of VOCs on potato dextrose agar (PDA)-containing Petri dishes. Each dish (total volume 70 mL) contained 20 mL of PDA medium. VOC concentrations were standardized according to the 50 mL headspace volume. All sealed dishes were incubated at 25 °C for 15 days, followed by the calculation of mycelial growth inhibition rates as outlined in Section 2.2.
The inhibition rate of V. dahliae spore germination was determined using a modified method [18]. A 1 μL dose of VOCs was applied to a spore suspension with a concentration of 1 × 106 spores/mL. The spore germination rate was calculated as the number of germinated spores divided by the total number of spores in the same field of view, with germination defined as the germ tube length exceeding half the spore diameter. The inhibition rate was computed as follows:
where Cg represents the germination rate of the control group, and Tg represents the germination rate of the treatment group.
2.5. Transcriptome Analysis of Different Solid Media
CEF642N was inoculated onto various solid media and allowed to grow for 15 days. The mycelium was then scraped using a scalpel, flash-frozen in liquid nitrogen, and sent to Personal Biotechnology Co., Ltd. (Shanghai, China) for transcriptome sequencing. For the GYESA and YPDA media, one replicate was prepared for every five dishes, while for the CA medium, one replicate was prepared for every six dishes. Each experiment was repeated three times.
2.6. Statistical Analyses
Statistical analyses were performed using SPSS 19.0, employing the least significant difference (LSD) test and one-way analysis of variance (ANOVA) for multiple comparisons. Statistical significance (p < 0.05) is denoted in figure legends using distinct lowercase letters. Data are expressed as means ± standard deviation (SD). All experiments were independently repeated at least three times to ensure reproducibility.
3. Results
3.1. Inhibitory Effects of Total VOCs from Various Solid Media
The total VOCs produced by CEF642N exhibited varying inhibitory effects against Vd076 depending on the culture medium. While CEF642N VOCs showed no inhibitory efficacy against the pathogen when cultured on CA medium (Figure S1), strong inhibitory effects were observed when CEF642N was grown on GYESA and YPDA media (Figures S2 and S3). Specifically, inhibition rates of 75.04% and 78.88% were recorded on the fifteenth day of the double Petri dish assay for the GYESA and YPDA media, respectively (Figure 1). These differences may be attributed to variations in biomass, as well as the types and concentration of VOCs produced. It is hypothesized that CEF642N generates volatiles with potent antifungal activity against V. dahliae when cultured on GYESA and YPDA media.
Figure 1.
Inhibitory effect of total VOCs produced by CEF642N on Verticillium dahliae across three media. (A) Photographs of CEF642N and Vd076 at day 15 of double Petri dish assay. (B) Time course of Vd076 inhibition rates by total VOCs produced by CEF642N in different media. CG: control group; TG: treatment group.
3.2. Identification and Comparative of CEF642N VOCs from Different Solid Media
The VOCs produced by CEF642N mycelium on CA, GYESA, and YPDA media were analyzed using HS-SPME-GC-MS, yielding 593 peaks, of which 496 were annotatable VOCs. Principal component analysis (PCA) revealed that the cumulative contribution of the first two principal components (PC1: 30.0%; PC2: 23.3%) was 52.3%. Biological replicates from the CA and YPDA media formed compact clusters, while those from the GYESA medium were more dispersed (Figure 2A). Differential VOC expression was determined using |log2 FoldChange| > 1 and p-value < 0.05 (Figure 2B). The GYESA_vs_CA comparison group exhibited 65 up-regulated, 17 down-regulated, and 414 non-significant VOCs. Similarly, the YPDA_vs_CA group had 110 up-regulated, 38 down-regulated, and 348 non-significant VOCs, while the YPDA_vs_GYESA group showed 25 up-regulated, 23 down-regulated, and 448 non-significant VOCs. Volcano plots (Figure 2C–E) indicated that the GYESA and YPDA media produced more up-regulated VOCs compared to the CA medium, while the GYESA and YPDA media exhibited similar VOC profiles. Venn diagram analysis revealed 52 shared differential VOCs between the GYESA_vs_CA and YPDA_vs_CA groups (Figure 2F).

Figure 2.
Analysis of total VOCs produced by CEF642N across different media. (A) PCA score plot of VOCs. (B) Number of up-regulated, down-regulated, and non-significant VOCs in each comparison group. (C–E) Volcano plots of VOCs in GYESA_vs_CA, YPDA_vs_CA, and YPDA_vs_GYESA groups. (F) Venn diagram of differential VOCs across comparison groups.
A total of 12 annotatable VOCs with relative quantitation values > 1 were identified (Table S2), including ethanol, 1,3-octadiene, 2-butenal, 3-octanone, 1-octen, 6-methyl-, 1-octen-3-one, 3-octanol, 2-octenal, (E)-, 1-octen-3-ol, oxirane, hexyl-, 2-octen-1-ol, (E)-, and methyl 2,2-difluro-3-oxopentanoate. The top three VOCs by percentage and relative quantitation value in each medium was as follows (Figure 3A,B): YPDA medium was 1-octen-3-ol (9.79%; 5.30), 1-octen, 6-methyl- (7.49%; 4.05), and 1-octen-3-one (6.69%; 3.62); GYESA medium was 1-octen-3-ol (16.18%; 11.23), 1-octen-3-one (7.38%; 5.12), and 2-octenal, (E)- (6.26%; 4.34); and CA medium was 1-octen-3-ol (14.41%; 8.93), oxirane, hexyl- (9.02%; 5.59), and 3-octanone (6.28%; 3.89). Clustered heatmap analysis revealed significant differences in the major VOCs among different media (Figure 3C).

Figure 3.
Analysis of major VOCs produced by CEF642N across different media. (A) Stacked plot of VOCs percentages. (B) Stacked plot of VOCs relative quantitative values. (C) Heatmap of major VOCs clustering across media.
By analyzing the log2-transformed ratios of the mean relative quantitative values of the primary VOCs across the culture media, it was evident that the concentrations of 1-octene, 6-methyl-, and 1-octen-3-one were significantly higher in the GYESA and YPDA media compared to the CA medium (Figure 4A). Furthermore, the VOCs produced by GYESA and YPDA exhibited substantially greater inhibitory effects on Vd076 than those from the CA medium, with inhibition rates of 75.04%, 78.88%, and −4.19%, respectively. A comparative analysis of the major components of the three media, without considering biomass, revealed that the percentage and relative quantitative values of 2-butenal, 1-octene, 6-methyl-, 1-octen-3-one, 3-octanol, 2-octenal, (E)-, and 2-octen-1-ol, (E)- were positively correlated with their respective inhibition rates against V. dahliae (Figure 4B). Integrating the percentage and relative quantitative values of the primary components with a comprehensive analysis of inhibition rates, it was hypothesized that the elevated levels of 1-octene, 6-methyl-, and 1-octen-3-one in GYESA and YPDA likely contributed to their higher inhibition rates compared to the CA medium. This hypothesis aligns with previous findings, demonstrating the significantly antifungal activity of 1-octen-3-one against V. dahliae [14].

Figure 4.
Comparative analysis of primary VOCs and their correlation with inhibition rates. (A) Log2-transformed ratios of primary VOCs relative quantitation values in GYESA and YPDA media compared to CA medium. (B) Correlation analysis of relative quantitative values and percentages of major VOCs with inhibition rate.
3.3. In Vitro Antifungal Activity
The antifungal activity of total VOCs from the GYESA and YPDA media were significantly higher than that of the CA medium. In addition to previously identified antifungal VOCs (e.g., 3-octanone, 1-octen-3-ol, 2-octen-1-ol, (E)-, and 1-octen-3-one; [14]), standardized samples of 3-octanol and 2-octenal, (E)- were tested. At a concentration of 600 μL/L, 3-octanol and 2-octenal, (E)- inhibited mycelial growth of V. dahliae by 73.29% and 100%, respectively (Figure 5), with the median effect concentration (EC50) of 493.0 and 404.4 μL/L (Table S3). The EC50 values for 3-octanol and 2-octenal, (E)- were higher than those of 3-octanone but lower than 1-octen-3-one, and comparable to 1-octen-3-ol and 2-octen-1-ol, (E)- [14]. Time course revealed that inhibition by 3-octanol increased initially before declining, while inhibition by 2-octenal, (E)- decreased steadily over time (Figure S4).

Figure 5.
Inhibition of Vd076 by 3-octanol and 2-octen-1-ol, (E)-. (A) Photographs of Vd076 treated with varying concentrations of 3-octanol and 2-octen-1-ol, (E)- at day 15. (B) Inhibition rates of Vd076 at day 15.
3.4. Transcriptome Analysis of Mycelium in Different Solid Media
3.4.1. Enrichment Analysis of Fatty Acid Metabolism-Related Genes
Fatty acid metabolism-related genes, which are precursors for the biosynthesis of antifungal VOCs such as 1-octen-3-ol [14], were enriched in CEF642N. Gene Ontology (GO) enrichment analysis revealed significant involvement in lipid metabolic process and lipid biosynthetic process across all comparison groups. Kyoto Encyclopedia of Genes and Genomes (KEGG) enrichment analysis indicated pathways such as fatty acid degradation (GYESA_vs_CA), biosynthesis of unsaturated fatty acids, fatty acid biosynthesis, arachidonic acid metabolism, and fatty acid degradation (YPDA_vs_CA and YPDA_vs_GYESA) (Figure 6A–C). The expression of genes associated with key differential KEGG enrichment pathways was higher in the YPDA medium compared to the CA medium. This included genes involved in the unsaturated fatty acid biosynthesis pathway (scaffold6.g636, scaffold1.g711, and scaffold3.g286), the fatty acid biosynthetic pathways (scaffold4.g701, scaffold4.702, scaffold1.g494, scaffold8.g10, and scaffold10.g186), the arachidonic acid metabolic pathways (scaffold8.g178 and scaffold1.g597), and the fatty acid degradation pathway (scaffold4.g199, scaffold1.g1249, and scaffold2.g759) (Figure S7).

Figure 6.
GO and KEGG enrichment analysis of fatty acid metabolism-related genes in CEF642N. (A–C) Enrichment analysis for GYESA_vs_CA, YPDA_vs_CA, and YPDA_vs_GYESA groups.
3.4.2. Expression of Genes Related to Eight-Carbon VOCs Biosynthesis
Eight-carbon volatiles, which contribute to the distinct scent of many fungi, are oxylipin molecules involved in various biological processes. These compounds are produced through the oxidation and cleavage of linoleic acid [19,20]. Lipoxygenase (LOX) and lipid hydroperoxide lyase (HPL) are the two most important enzymes [21,22] in its biosynthesis (Figure 7A). A genomic search for LOX in the CEF642N genome identified only one gene, scaffold1.g29, and no HPL-related genes were detected. However, 44 genes associated with lyase enzymes were identified (Figure 7B). Among the three different media, the LOX gene scaffold1.g29 exhibited the highest expression in the GYESA medium, followed by the YPDA medium (Figure 7C). Lyase enzyme genes, including scaffold2.g848, scaffold3.g19, scaffold4.g715, scaffold10.g134, scaffold5.g321, scaffold5.g359, scaffold5.g426, scaffold3.g748, scaffold10.g153, scaffold2.g16, scaffold4.g88, scaffold9.g305, scaffold9.g306, scaffold5.g776, scaffold6.g279, and scaffold8.g576, showed higher expression in the YPDA medium compared to the CA medium (Figure 7D).

Figure 7.
Biosynthetic pathways and gene expression analysis of eight-carbon VOCs in CEF642N. (A) Proposed pathways for eight-carbon VOCs production [23,24,25,26]. (B) Number of LOX and lyase genes in CEF642N genome. (C) Expression of LOX gene (scaffold1.g29) across media. (D) Heatmap of lyase gene expression across media.
4. Discussion
Agricultural soils are commonly treated with pesticides to control nematodes, soil-borne pathogens, and weeds, particularly in preparation for planting high-value cash crops. Ideally, pesticide should selectively target harmful organisms; however, fumigants, a class of pesticides with broad biocidal activity, often affect many non-target soil organisms [27]. Plant endophytic fungi produce VOCs that hold significant potential for biological control due to their small molecular size and ease of dispersal in plants and soils. These fungal VOCs offer an environmentally benign, cost-effective, and sustainable solution for agricultural practices [28].
The inhibitory effect of VOCs produced by T. purpureogenus CEF642N on V. dahliae varied across three different media: minimal inhibitory activity was observed on the CA medium, while significant inhibition occurred on the GYESA and YPDA media (Figure 1). This suggests that VOC production by CEF642N is media-dependent. To investigate this further, we conducted a comparative metabolomic analysis of VOCs across the three media (Figure 2 and Figure 3). The results revealed that 1-octen-3-one and 1-octene, 6-methyl- were present in significantly higher concentrations in the GYESA and YPDA media compared to the CA medium (Figure 4). Notably, 1-octen-3-one demonstrated strong antagonistic activity against V. dahliae mycelium growth [14], which may explain the higher rates observed in the GYESA and YPDA media. Additionally, 3-octanol and 2-octenal, (E)- were identified as major VOCs in the GYESA and YPDA media, accounting for 1.49%, 2.00% (3-octanol) and 6.26%, 6.49% (2-octenal, (E)-), respectively. These compounds significantly inhibited mycelial growth and spore germination of V. dahliae (Figure 5 and Figure S6). 3-Octenal, a safe fungal VOC, was reported to inhibit Botrytis cinerea by inducing autophagy, reducing cell viability, and suppressing spore germination [29]. Similarly, trans-2-octenal derived from Lactiplantibacillus plantarum exhibits antifungal activity against Aspergillus niger CECT 2805 [30]. In addition, Bacillus velezensis SEC-024A showed strong antifungal effects against industrial hemp wilt, with VOCs identified as the main antifungal components. Among these, trans-2-octenal demonstrated broad-spectrum activity against soil-borne pathogens [31]. Furthermore, (E)-2-octenal inhibits the growth of postharvest pathogens (Neofusicoccum parvum and Penicillium italicum) by disrupting mitochondrial energy metabolism, suggesting its potential as a postharvest preservative for citrus and mango [32,33]. To our knowledge, this is the first report of significant antagonistic activity of 3-octanol and 2-octenal, (E)- against V. dahliae. These findings provide a theoretical foundation for developing biofumigants to control cotton Verticillium wilt.
Certain enzymes and SMs are uniquely synthesized through solid-state fermentation (SSF) owing to the distinctive physiological micro-environment established in this cultivation system. Higher yields of SMs are associated with increased transcription of biosynthetic genes, and studies on SSF enzyme production have identified SSF-specific genes, offering insights into their expression and regulation [34]. Fatty acids serve as precursors for eight-carbon VOCs, which exhibit significant antagonistic effect [35]. KEGG enrichment analyses of transcriptome data revealed that differentially expressed genes are primarily involved in unsaturated fatty acid biosynthesis and arachidonic acid metabolism, among other things (Figure 6). Arachidonic acid is metabolized via two pathways: the cyclooxygenase (COX) and LOX pathways [36]. Research on Marchantia polymorpha has shown that 1-octen-3-ol, the primary C8 product of arachidonic acid metabolism, undergoes further modification, including acetylation and redox reaction, to diversify C8 compounds [37].
Although eight-carbon VOCs play crucial roles in many biological activities, their biosynthetic pathways in fungi remain poorly understood. The synthesis of 1-octen-3-ol is relatively well documented, though some hypotheses lack sufficient evidence. Fungi utilize fatty acids to produce volatile compounds, which are subsequently oxidized and cleaved into short-chain VOCs. LOX, a key enzyme in oxylipin synthesis, catalyzes the initial step in the conversion of polyunsaturated fatty acids to oxylipins [38,39]. Its activity and transcriptional regulation are critical for oxylipin synthesis [40,41]. HPL, an enzyme downstream of LOX, cleaves LOX products into short-chain aldehydes and oxygenated acids [42,43]. For instance, adding linoleic acid to the culture medium enhanced 1-octen-3-ol production by Penicillium camemberti, particularly through increased HPL activity [44]. Similarly, in Agaricus bisporus, LOX and HPL are essential for 1-octen-3-ol synthesis from linoleic acid [45], with AbLOX and AbHPL identified as the key enzymes [46]. Shiitake mushrooms cultivated on maize cobs produced the highest levels of eight-carbon VOCs [47]. Transcriptomics analysis of selected genes, combined with VOC profiling at different developmental phases, has proven effective in identifying enzymes involved in fungal VOC biosynthesis [48]. In this study, the analysis of differential expression patterns of key genes involved in the eight-carbon VOCs biosynthesis pathway in CEF642N under different culture media conditions identified critical targets for further screening to enhance 1-octen-3-ol production.
5. Conclusions
This study employed the OSMAC strategy to investigate the antagonistic activity of VOCs produced by T. purpureogenus CEF642N against V. dahliae across three media. Comparative metabolomic analysis revealed differences in VOC composition, particularly the higher proportion of 1-octen-3-one in the GYESA and YPDA media, which likely explains the observed differences in the inhibition rates. The primary antifungal VOCs, 3-octanol and 2-octenal, (E)-, demonstrated significant inhibitory effects on V. dahliae mycelial growth and spore germination, highlighting their potential as green pesticides or biofumigants for controlling cotton Verticillium wilt. Transcriptome analysis of mycelia grown on different media identified differentially expressed genes involved in lipid metabolism and eight-carbon VOCs biosynthesis, providing a theoretical basis for future gene screening and biosynthesis studies.
Supplementary Materials
The following supporting information can be downloaded at: https://www.mdpi.com/article/10.3390/jof11050332/s1. Table S1: Composition of three solid culture media; Table S2: Analysis of major VOCs (relative quantitative value > 1) produced by T. purpureogenus CEF642N in different culture media; Table S3: EC50 value of 3-octanol and 2-octenal, (E)- for inhibiting mycelial development of V. dahliae; Figure S1: Time course of double Petri dish assay between CEF642N and Vd076 on CA medium; Figure S2: Time course of double Petri dish assay between CEF642N and Vd076 on GYESA medium; Figure S3: Time course of double Petri dish assay between CEF642N and Vd076 on YPDA medium; Figure S4: Inhibition rates of V. dahliae mycelial growth at different time points under varying concentrations of 3-octanol and 2-octenal, (E)-; Figure S5: Images of V. dahliae spore germination after treatment with 1 μL of 3-octanol and 2-octenal, (E)-; Figure S6: Inhibition rate of V. dahliae spore germination following treatment with 1 μL of 3-octanol and 2-octenal, (E)-; Figure S7: Heatmap on differential gene expression in fatty acid metabolic pathway from KEGG enrichment analysis of different solid media.
Author Contributions
Writing—review and editing, writing—original draft, visualization, software, methodology, data curation, P.L.; writing—review and editing, validation, investigation, formal analysis, Y.Z.; writing−review and editing, methodology, data curation, conceptualization, H.F.; visualization, software, resource, J.Z.; resources, project administration, L.Z.; supervision, resources, funding acquisition, conceptualization, H.Z.; supervision, resources, funding acquisition, project administration, F.W.; validation, resources, funding acquisition, formal analysis, Z.F. All authors have read and agreed to the published version of the manuscript.
Funding
This research was funded by the Tianshan Innovation team project (2024D14007), the Key Research and Development Program of Xinjiang Uygur Autonomous Region (2024B02003), the Xinjiang Tianchi Talents Program (TCYC2023TP02), and the Agricultural Science and Technology Innovation Program of Chinese Academy of Agricultural Sciences.
Institutional Review Board Statement
Not applicable.
Informed Consent Statement
Not applicable.
Data Availability Statement
The original contributions presented in this study are included in the article/Supplementary Materials. Further inquiries can be directed to the corresponding authors.
Conflicts of Interest
The authors declare no conflicts of interest.
Abbreviations
The following abbreviations are used in this manuscript:
| VOCs | Volatile organic compounds |
| OSMAC | One strain many compounds |
| LOX | Lipoxygenase |
| SMs | Secondary metabolites |
| HS-SPME | Headspace solid-phase microextraction |
| PAL | Prep And Load |
| GC-MS | Gas chromatography–mass spectrometry |
| CA | Czapek agar |
| GYESA | Glucose yeast extract soluble starch agar |
| YPDA | Yeast extract peptone dextrose agar |
| PDA | Potato dextrose agar |
| LSD | Least significant difference |
| ANOVA | Analysis of variance |
| SD | Standard deviation |
| PCA | Principal component analysis |
| EC50 | Median effect concentration |
| GO | Gene Ontology |
| KEGG | Kyoto Encyclopedia of Genes and Genomes |
| HPL | Hydroperoxide lyase |
| SSF | Solid-state fermentation |
References
- Song, R.; Li, J.; Xie, C.; Jian, W.; Yang, X. An overview of the molecular genetics of plant resistance to the Verticillium wilt pathogen Verticillium dahliae. Int. J. Mol. Sci. 2020, 21, 1120. [Google Scholar] [CrossRef] [PubMed]
- Thambugala, K.M.; Daranagama, D.A.; Phillips, A.J.L.; Kannangara, S.D.; Promputtha, I. Fungi vs. Fungi in biocontrol: An overview of fungal antagonists applied against fungal plant pathogens. Front. Cell. Infect. Microbiol. 2020, 10, 604923. [Google Scholar] [CrossRef] [PubMed]
- Kaddes, A.; Fauconnier, M.; Sassi, K.; Nasraoui, B.; Jijakli, M. Endophytic fungal volatile compounds as solution for sustainable agriculture. Molecules 2019, 24, 1065. [Google Scholar] [CrossRef] [PubMed]
- Razo-Belman, R.; Ozuna, C. Volatile organic compounds: A review of their current applications as pest biocontrol and disease management. Horticulturae 2023, 9, 441. [Google Scholar] [CrossRef]
- Elsherbiny, E.A.; Amin, B.H.; Aleem, B.; Kingsley, K.L.; Bennett, J.W. Trichoderma volatile organic compounds as a biofumigation tool against late blight pathogen Phytophthora infestans in postharvest potato tubers. J. Agric. Food Chem. 2020, 68, 8163–8171. [Google Scholar] [CrossRef]
- Xing, M.; Zhao, J.; Zhang, J.; Wu, Y.; Khan, R.A.A.; Li, X.; Wang, R.; Li, T.; Liu, T. 6-Pentyl-2H-pyran-2-one from Trichoderma erinaceum is fungicidal against litchi downy blight pathogen Peronophythora litchii and preservation of Litchi. J. Agric. Food Chem. 2023, 71, 19488–19500. [Google Scholar] [CrossRef]
- Ning, M.; Guo, Q.; Guo, P.; Cui, Y.; Wang, K.; Du, G.; Wang, Z.; Yuan, Y.; Yue, T. Biocontrol activity of Kluyveromyces marxianus YG-4 against Penicillium expansum LPH9 on apples. Int. J. Food Microbiol. 2025, 427, 110943. [Google Scholar] [CrossRef]
- Takahashi, J.A.; Teles, A.P.C.; Bracarense, A.d.A.P.; Gomes, D.C. Classical and epigenetic approaches to metabolite diversification in filamentous fungi. Phytochem. Rev. 2013, 12, 773–789. [Google Scholar] [CrossRef]
- Schuller, A.; Studt-Reinhold, L.; Strauss, J. How to completely squeeze a fungus—Advanced genome mining tools for novel bioactive substances. Pharmaceutics 2022, 14, 1837. [Google Scholar] [CrossRef]
- Bode, H.B.; Bethe, B.; Hofs, R.; Zeeck, A. Big effects from small changes: Possible ways to explore nature’s chemical diversity. ChemBioChem 2002, 3, 619–627. [Google Scholar] [CrossRef]
- Pan, R.; Bai, X.; Chen, J.; Zhang, H.; Wang, H. Exploring structural diversity of microbe secondary metabolites using OSMAC strategy: A literature review. Front. Microbiol. 2019, 10, 294. [Google Scholar] [CrossRef] [PubMed]
- Pinedo-Rivilla, C.; Aleu, J.; Duran-Patron, R. Cryptic metabolites from marine-derived microorganisms using OSMAC and epigenetic approaches. Mar. Drugs 2022, 20, 84. [Google Scholar] [CrossRef] [PubMed]
- Hu, X.Y.; Li, X.M.; Liu, H.; Wang, B.G.; Meng, L.H. Mining new meroterpenoids from the marine red alga-derived endophytic Penicillium chermesinum EN-480 by comparative transcriptome analysis. Bioorg. Chem. 2022, 128, 106021. [Google Scholar] [CrossRef]
- Li, P.; Wei, F.; Feng, H.; Zhao, L.; Zhang, Y.; Zhou, J.; Feng, Z.; Zhu, H. Talaromyces purpuregenus CEF642N as a promising biocontrol agent for cotton disease control. J. Agric. Food Chem. 2025, 73, 2760–2772. [Google Scholar] [CrossRef]
- Zhang, Y.; Cui, L.; Liu, R.; Feng, Z.; Feng, H.; Zhou, J.; Zhao, L.; Wei, F.; Zhu, H. In the coevolution of cotton and pathogentic fungi, resistant cotton varieties lead to an escalation in the virulence of Verticillium dahliae. Ecotoxicol. Environ. Saf. 2025, 290, 117730. [Google Scholar] [CrossRef]
- Tang, T.; Wang, F.; Huang, H.; Xie, N.; Guo, J.; Guo, X.; Duan, Y.; Wang, X.; Wang, Q.; You, J. Antipathogenic activities of volatile organic compounds produced by Bacillus velezensis LT1 against Sclerotium rolfsii LC1, the pathogen of southern blight in Coptis chinensis. J. Agric. Food Chem. 2024, 722, 10282–10294. [Google Scholar] [CrossRef]
- Wang, Z.; Wang, Z.; Lu, B.; Quan, X.; Zhao, G.; Zhang, Z.; Liu, W.; Tian, Y. Antagonistic potential of Trichoderma as a biocontrol agent against Sclerotinia asari. Front. Microbiol. 2022, 13, 997050. [Google Scholar] [CrossRef]
- Pei, Y.; Zhu, Y.; Jia, Y.; Ge, X.; Li, X.; Li, F.; Hou, Y. Molecular evidence for the involvement of cotton GhGLP2, in enhanced resistance to Verticillium and Fusarium Wilts and oxidative stress. Sci. Rep. 2020, 10, 12510. [Google Scholar] [CrossRef]
- Combet, E.; Henderson, J.; Eastwood, D.C.; Burton, K.S. Eight-carbon volatiles in mushrooms and fungi: Properties, analysis, and biosynthesis. Mycoscience 2006, 47, 317–326. [Google Scholar] [CrossRef]
- Pennerman, K.K.; Yin, G.; Bennett, J.W. Eight-carbon volatiles: Prominent fungal and plant interaction compounds. J. Exp. Bot. 2022, 73, 487–497. [Google Scholar] [CrossRef]
- Singh, P.; Arif, Y.; Miszczuk, E.; Bajguz, A.; Hayat, S. Specific roles of lipoxygenases in development and responses to stress in plants. Plants 2022, 11, 979. [Google Scholar] [CrossRef] [PubMed]
- Matsui, K.; Engelberthe, J. Green leaf volatiles—The forefront of plant responses against biotic attack. Plant Cell Physiol. 2022, 63, 1378–1390. [Google Scholar] [CrossRef] [PubMed]
- Wurzenberger, M.; Grosch, W. Origin of the oxygen in the products of the enzymatic cleavage reaction of linoleic acid to 1-octen-3-ol and 10-oxo-trans-8-decenoic acid in mushrooms (Psalliota bispora). BBA-Lipid. Lipd Metab. 1984, 794, 18–24. [Google Scholar] [CrossRef]
- Wurzenberger, M.; Grosch, W. The formation of 1-octen-3-ol from the 10-hydroperoxide isomer of linoleic acid by a hydroperoxide lyase in mushrooms (Psalliota bispora). BBA-Lipid. Lipd Metab. 1984, 794, 25–30. [Google Scholar] [CrossRef]
- Wurzenberger, M.; Grosch, W. Stereochemistry of the cleavage of the 10-hydroperoxide isomer of linoleic acid to 1-octen-3-ol by a hydroperoxide lyase from mushrooms (Psalliota bispora). BBA-Lipid. Lipd Metab. 1984, 795, 163–165. [Google Scholar] [CrossRef]
- Ferrari, R.; Lacaze, I.; Faouder, P.L.; Bertrand-Michel, J.; Oger, C.; Galano, J.; Durand, T.; Moularat, S.; Tong, L.C.H.; Boucher, C.; et al. Cyclooxygenases and lipoxygenases are used by the fungus Podospora anserina to repel nematodes. BBA-Gen. Subjects 2018, 1862, 2174–2182. [Google Scholar] [CrossRef]
- Ibekwe, A.M. Effects of fumigants on non-target organisms in soils. Adv. Agron. 2004, 83, 1–35. [Google Scholar]
- Kanchiswamy, C.N.; Malnoy, M.; Maffei, M.E. Bioprospecting bacterial and fungal volatiles for sustainable agriculture. Trends Plant Sci. 2015, 20, 206–211. [Google Scholar] [CrossRef]
- Zhang, X.; Li, G.; Zhang, Z.; Tian, S. 3-Octanol controls gray mold on postharvest fruit by inducing autophagy of Botrytis cinerea. Postharvest Biol. Tec. 2023, 205, 112525. [Google Scholar] [CrossRef]
- Simone, N.D.; Lopez, L.; Ciudad, C.S.; Scauro, A.; Russo, P.; Rodriguez, J.; Spano, G.; Martinez, B. Antifungal activity of Lactiplantibacillus plantarum isolated from fruit and vegetables and detection of novel antifungal VOCs from fungal-LAB co-cultures. Food Biosci. 2024, 58, 103824. [Google Scholar] [CrossRef]
- Wang, T.; Li, W.; Wang, F.; Li, J.; Qin, J.; Song, Z.; Xu, J.; Qiu, H.; Cheng, Y. Biocontrol potential of Bacillus velezensis SEC-024A against southern blight of industrial hemp. Ind. Crop. Prod. 2024, 222, 119767. [Google Scholar] [CrossRef]
- Luo, Y.; Chen, X.; Chen, J.X.; Zhang, Y.; Ouyang, Q.; Tao, N. (E)-2-Octenal suppresses the growth of a prochlora-resistant Penicillium italicum strain and its potential antifungal mechanisms. Postharvest Biol. Technol. 2023, 205, 112515. [Google Scholar] [CrossRef]
- Tan, X.; Jiang, X.; Reymick, O.O.; Zhu, C.; Tao, N. (E)-2-Octenal inhibits Neofusicoccum parvum growth by disrupting mitochondrial energy metabolism and is a potential preservative for postharvest mango. Food Res. Int. 2025, 201, 115639. [Google Scholar] [CrossRef] [PubMed]
- Barrios-Gonzalez, J. Solid-state fermentation: Physiology of solid medium, its molecular basis and applications. Process Biochem. 2012, 47, 175–185. [Google Scholar] [CrossRef]
- Karrer, D.; Weigel, V.; Hoberg, N.; Atamasov, A.; Ruhl, M. Biotransformation of [U-13C] linoleic acid suggests two independent ketonic- and aldehydic cycles with C8-oxylipin biosynthesis in Cyclocybe aegerita (V. Brig.) Vizzini. Mycol. Prog. 2021, 20, 929–940. [Google Scholar] [CrossRef]
- Haeggstrom, J.Z.; Funk, C.D. Lipoxygenase and leukotriene pathways: Biochemistry, biology, and roles in disease. Chem. Rev. 2011, 111, 5866–5898. [Google Scholar] [CrossRef]
- Kihara, H.; Tanaka, M.; Yamato, K.T.; Horibata, A.; Yamada, A.; Kita, S.; Ishizaki, K.; Kajikawa, M.; Fukuzawa, H.; Kohchi, T.; et al. Arachidonic acid-dependent carbon-eight volatile synthesis from wounded liverwort (Marchantia polymorpha). Phytochemistry 2014, 107, 42–49. [Google Scholar] [CrossRef]
- Hajeyah, A.A.; Griffiths, W.J.; Wang, Y.; Finch, A.J.; O’Donnell, V.B. The biosynthesis of enzymatically oxidized lipids. Front. Endocrinol. 2020, 11, 591819. [Google Scholar] [CrossRef]
- Orban, A.; Weber, A.; Herzog, R.; Hennicke, F.; Ruhl, M. Transcriptome of different fruiting stages in the cultivated mushroom Cyclocybe aegerita suggests a complex regulation of fruiting and reveals enzymes putatively involved in fungal oxylipin biosynthesis. BMC Genomics 2021, 22, 324. [Google Scholar] [CrossRef]
- Tasaki, Y.; Kobayashi, D.; Sato, R.; Hayashi, S.; Joh, T. Variations in 1-octen-3-ol and lipoxygenase gene expression in the oyster mushroom Pleurotus ostreatus according to fruiting body development, tissue specificity, maturity, and postharvest storage. Mycoscience 2019, 60, 170–176. [Google Scholar] [CrossRef]
- Liu, H.; Zhang, X.; Chen, W.; Wang, C. The regulatory functions of oxylipins in fungi: A review. J. Basic Microb. 2023, 63, 1073–1084. [Google Scholar] [CrossRef] [PubMed]
- Matsui, K.; Sasahara, S.; Akakabe, Y.; Kajiwara, T. Linoleic acid 10-hydroperoxide as an intermediate during formation of 1-octen-3-ol from linoleic acid in Lentinus decadetes. Biosci. Biotechnol. Bioch. 2003, 67, 2280–2282. [Google Scholar] [CrossRef] [PubMed]
- Stolterfoht, H.; Rinnofner, C.; Winkler, M.; Pichler, H. Recombinant lipoxygenases and hydroperoxide lyases for the synthesis of green leaf volatiles. J. Agric. Food Chem. 2019, 67, 13367–13392. [Google Scholar] [CrossRef]
- Husson, F.; Thomas, M.; Kermasha, S.; Belin, J. Effect of linoleic acid induction on the production of 1-octen-3-ol by the lipoxygenase and hydroperoxide lyase activities of Penicillium camemberti. J. Mol. Catal. B Enzym. 2002, 19–20, 363–369. [Google Scholar] [CrossRef]
- Husson, F.; Bompas, D.; Kermasha, S.; Belin, J.M. Biogeneration of 1-octen-3-ol by lipoxygenase and hydroperoxide lyase activities of Agaricus bisporus. Process Biochem. 2001, 37, 177–182. [Google Scholar] [CrossRef]
- Su, T.; Chen, Y.; Liu, H.; Gao, Y.; Guo, J.; Li, Y.; Qi, Y.; Qiu, L. The biosynthesis of 1-octene-3-ol by a multifunctional fatty acid dioxygenase and hydroperoxide lyase in Agaricus bisporus. J. Fungi 2022, 8, 827. [Google Scholar] [CrossRef]
- Li, W.; Chen, W.; Wang, J.; Feng, J.; Wu, D.; Zhang, Z.; Zhang, J.; Yang, Y. Effects of enzymatic reaction on the generation of key aroma volatiles in shiitake mushroom at different cultivation substrates. Food Sci. Nutr. 2021, 9, 2247–2256. [Google Scholar] [CrossRef]
- Orban, A.M.; Ruhl, M. Identification of volatile producing enzymes in higher fungi: Combining analytical and bioinformatic methods. Method. Enzymol. 2022, 664, 221–242. [Google Scholar]
Disclaimer/Publisher’s Note: The statements, opinions and data contained in all publications are solely those of the individual author(s) and contributor(s) and not of MDPI and/or the editor(s). MDPI and/or the editor(s) disclaim responsibility for any injury to people or property resulting from any ideas, methods, instructions or products referred to in the content. |
© 2025 by the authors. Licensee MDPI, Basel, Switzerland. This article is an open access article distributed under the terms and conditions of the Creative Commons Attribution (CC BY) license (https://creativecommons.org/licenses/by/4.0/).







